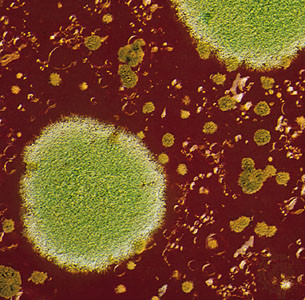
image

My million-dollar Brooklyn condo has mold

Our narrator's moldy insulation and wall stripped bare.
Courtesy of the author
Mold. It strikes fear in the heart of many a renter and owner, and for good reason. If you're not concerned about mold, you might want to put it on your radar, as it can cause health problems and damage property, and it's expensive to get rid of. This is the story of a Brooklyn condo owner who discovered way too late that her apartment—and building—had a mold issue.
Read on for her (still ongoing) tale of woe about her two-bedroom, two-bath apartment that despite its $1 million-plus price tag, didn't escape the scourge.

Condo living in brownstone Brooklyn
I live on the border of Carroll Gardens and Red Hook—otherwise known as the Columbia Street Waterfront District. It’s a two-bedroom, two-bath apartment, and it’s in a brownstone that about 10 years ago was gutted and converted into four units. The developer redid the interior of the original structure and then tacked on an extra bedroom and bathroom in the back. And he did a s----y job, apparently.
It’s a self-managed condo, which means that we all pay $150 in common charges a month [for building insurance]. That goes into a pool if we were to ever need it, but we all take turns taking out the garbage and shoveling the steps. We just do stuff ourselves because there are no common charges essentially, unless there’s some sort of assessment.
We moved in about two-and-a-half years ago. When we moved in [the previous owner] was honest and said there had been a leak in that bedroom and they thought they resolved it. When we bought the apartment there was a little spot on the ceiling. We did have the place inspected, and the inspector said nothing in his report related to mold or water issues.
My two sons, who are six and three years old, share that room as a bedroom. We had some sort of minor leak issue early on in there, nothing major, and that was addressed.
Not passing the smell test
Several months ago, over the summer, I was smelling mold in their room. It smelled like a strong mildew smell, like what you’d smell if you left a wet bathing suit in the sink for too long or something. In the space between the top and bottom bunk—the place where my very asthmatic three-year-old touches his face every night when he sleeps—had a little bubble under the paint And when I touched it, it was wet and literally peeled off in my hand.
I had somebody come and they told me they thought that we would have to cut a hole in the wall.
More than meets the eye
The first contractor who came cut open a space in the wall, pulled out the insulation and wrung it out on the floor. It was soaking wet. And then he showed me that on the flip side, it was covered in black mold. The small hole [in the wall] became a larger hole, and that became a larger hole until the whole wall had come down. The electrical had rotted. The beams had rotted. Ultimately, big chunks of my floor had to be removed because they’re wood and there was water underneath them and that area was molded. A chunk of the ceiling came off because it was also moldy.
How did this happen?
After many consultations, we determined that the most likely scenario is this: the material used to build the extension is called California Stucco, otherwise known as EIFS. Manufactures of the stuff are apparently tied up in a bunch of lawsuits. It’s essentially Styrofoam with some material on top of it. I spent a lot of time building up hatred for this material but then a very informed contractor told me it’s actually not a bad material, it's just very hard to apply properly.
We think that for whatever reason the workers didn’t put in some sort of waterproofing membrane before they put it down, and that there was probably a little moisture in there to begin with. Then the moisture, for almost a decade, just grew more and more mold. And also, there are a bunch of cracks that developed in the exterior that allowed more water to get in, and once it gets in it can’t get out. So it was just trapped in there, building up.
We did a water test; we poured water all over the roof and nothing happened on the wall. At this point we didn’t have a wall, we were just looking to see if something dripped, and nothing happened. So that confirms that it’s the wall’s fault.
When they took down the wall and [we] realized it was problematic, my upstairs neighbor [investigated his wall]. He had all this furniture against his wall [that he moved]... and his mold problem was worse than mine. You could see it coming through the paint. So his wall is now down, too. This is a whole-wall problem.

Sneaky and destructive
You only know you have it [when] you take off the wall. Unless you smell it. My sons’ bedroom was painted blue. It’s just not something you might spot. My upstairs neighbor never would have known. They had all their bookcases and dressers against that [bad] wall.
A tale of (at least) two contractors
And now we’re waiting ... We can’t rebuild the interior wall until the source of the water and mold issues—which is the exterior wall—is redone. That is done by a separate company. We’ve gone through all these contractors, and they have sub-specialists who are stucco guys. And they all have different ideas of how to do it, different materials they recommend.
[We’re now looking at] a concrete wall. They pulled out all the metal studs which had rusted, they pulled out all the electrical, which had rusted. You can stare up at the ceiling and the beams have rusted. They have to replace the joists because those have rusted right through and the person who’s prepared to rebuild the interior wall won’t start until we’ve found some who can both redo the exterior stucco and address a few interior issues related to the building structure.
It’s ongoing. We’ve had so many near misses with contractors. One took off with three grand of our money and now won’t respond to calls and I don’t have his last name. Another dude was supposed to start and then got a bigger job in Manhattan so he bailed. We’re still trying to find someone. A contractor came yesterday but he’s swamped and can’t “realistically start until mid November.” It’s horrible. It’s also very, very expensive.
Repair by committee
To complicate matters, the only way to access our exterior wall is to go through our neighbor's backyard... The guy in unit one [of the neighboring building] is a lawyer and got super litigious right off the bat. He is very uncomfortable with the fact that stuff would have to be done on his property and he sent us a really long list of questions and things he needed resolved before work could commence.
There’s a tree in the backyard that’s got branches that are rubbing against the wall, so I indicated that we’re going to have to trim the tree. One woman sent this long response saying she wants to know how the tree will be trimmed, it’s an old tree. I'm like, “It’s not f---ing bonsai. My son has asthma, we’re trimming the tree.”
Making it work
I’ve been sleeping on an air mattress for two-and-a-half months, because we gave our sons our bed. And also because if we let them sleep in the living room it meant everything in the house would shut down at 8 o’clock, and if I come home late I'm coming home into their bedroom. Am I supposed to eat on my bed? Where am I eating my dinner?
Who pays for it?
We went through our insurance company [to try to pay for the repairs and remediation]. Our coverage doesn’t include a scenario like this. They even sent a structural engineer to look at it, but apparently it’s just badly done, and that’s not covered—not a penny. It’s not covered by the insurance in my unit because it's a problem caused by an exterior issue, and it’s not covered by the condo’s insurance because that only covers if there’s a flood, not something like water damage over time.
I bought into a bad building.